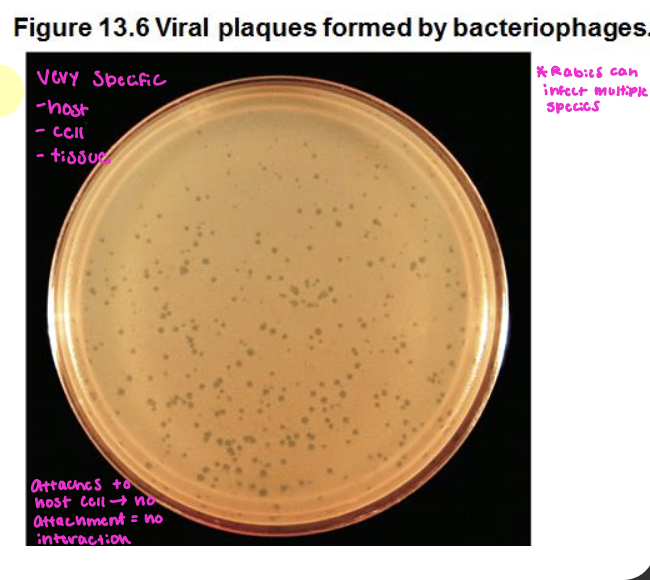

1/55
Looks like no tags are added yet.
Name | Mastery | Learn | Test | Matching | Spaced | Call with Kai |
|---|
No analytics yet
Send a link to your students to track their progress
Nonliving infections particles include
Viruses
Virophages
Viroids
Prions
Are viruses cells?
NO, they are not cells, they are obligate intracellular parasites/pathogens
cannot reproduce outside their host cell
The Novel Properties of Viruses
Inert macromolecules outside of a cell but become active inside a cell
DO NOT divide and grow = need host cell
Acellular (A = not)
Contain EITHER DNA OR RNA (not both), with a few exceptions
Genome can be dsDNA, ssDNA, dsRNA, or ssRNA
Usually ultramicroscopic in size, ranging from 10nm to 500nm = need an electron microscope to see
Have a proteinaceous capsid around genome; some have an envelope around the capsid
Replicate in an assembly line manner using the enzymes and organelles of a host cell
NO ribosomes = no protein synthesis
No ATP-generating mechanism
Are infectious! Many viruses are medically important
Herpes
Huge family of viruses
Chicken pox, cold sores, STI
Icosahedral shape!
HPV
Human Papilloma Virus
Can show no symptoms, not necessarily sexual
Icosahedral shape

General Structure of Viruses: Capsids
ALL viruses have capsids!
Protein coats that enclose and protect their nucleic acid
Constructed from identical protein subunits called capsomeres
The capsid together with the nucleic acid form the nucleocapsid
NOTE: Our immune system DOES NOT like repeating units = the capsomeres
A good example would be the Rhinovirus - common cold

Capsid Structure types: Helical
Continuous helix of capsomers forming a cylindrical nucleocapsid

Capsid Structure types: Polyhedral (Icosahedral)
20 sided with 12 corners
Vary in number of capsomers
Each capsomer may be made of 1 or several proteins
Some are enveloped = membrane EXTERNAL to capsid (outer)

What shape is the rabies virus?
It is bullet shaped

The viral envelope (how it’s derived)
The viral envelope is derived from the host cell membrane
Some animal viruses - *NOT on bacteriophages b/c bacteria have cell walls
Meaning bacteria can pierce bacterial cell walls while animal cells need that envelope to help fuse into the membrane(we don’t have cell walls)
acquired when virus leaves or buds through the host cell
exposed proteins on the outside envelope, called spikes/peplomers are essential for: binding to receptor and infectivity of the host cell
Those without an envelope = Naked viruses ‘
NOTE: Proteins on nucleocapsid or envelope interact with complementary host cell receptors!

Envelope: Functions
NOTE: is REQUIRED for enveloped viruses
Protects the nucleic acid when the virion is OUTSIDE the host cell
Is used to: bind to receptor and infect the host cell
If there is no envelope = Naked virus (capsid binds to host cell)
Advantages of the Envelope
Is similar to host membranes so helps the virus evade host immune response for a time
Molecular mimicry = virus looks like host cell
Required for infectivity: fuses with host cell membrane = no envelope = no infectivity
True for enveloped viruses!
Enveloped viruses are easier to kill on surfaces BUT harder for the body to detect
Opposite for naked viruses
Disadvantages of Virus envelope
Anything that damages a cell membrane will damage the viral envelope = like soap!!
So = damaged by environmental conditions
Temp, pH, pressure, toxins, detergents, etc
Damages to viral envelope = no infectivity!
So, naked viruses are → More resistant to damaging environmental factors
Why is resistance to environmental conditions important?
Naked virus can persist! → While enveloped viruses cannot
Viruses with a damaged/destroyed cell envelope cannot interact with (complementary) molecule/host receptor
Growing Viruses (obligate intracellular pathogens)
Viruses must be grown on living cells
Animal viruses may be grown in living animals or in embryonated eggs or in cell structures (tissue culture)
Continuous cell lines
Bacteriophages form plaques on a lawn of bacteria
For infection: All viruses must interact with host cell receptor
Host receptor is complementary to molecule on virus (spike protein (peplomer))
Viruses are nonmotile
Chemical attraction involved = sense presence of host cell
Viral Replication of animal viruses
Replication of Animal Viruses
Must attach to host cell first
Entry and uncoating of animal viruses
At least three different mechanisms by which animal viruses enter a cell!
What are the three mechanisms that an animal virus uses to enter a cell?
Direct penetration: only nucleic acid enters host cell
For naked viruses ONLY
Membrane fusion: only nucleocapsid enters
For enveloped viruses ONLY
Endocytosis: entire enveloped OR naked virus enters the cell
Specific to animal cells!
Viruses that enter cell with capsid intact are uncoated inside the cell → the genetic information is floating around (nucleic acid)
Genome/Nucleic Acid has to be released into the cytoplasm for viral replication = enzymes needed

Release of animal viruses
Assembled animal viruses leave host cell in one of two ways!
Budding/blebbing: exocytosis; nucleocapsid binds to membrane which pinches off and sheds the viruses gradually (typically by enveloped viruses)
Lysis: virus released when cell dies and ruptures (typically for naked viruses)
Number of viruses released during lysis is variable
Poxvirus 3,000-4,000 released
Poliovirus >100,000 released
The process of budding in enveloped viruses & molecular mimicry
Molecular mimicry = enveloped virus looks like host cell due to presence of host cell membrane = but immune response will eventually recognize viral components
Virus budding will eventually kill host cell

Complex structure of viruses
Some bacteriophages have a polyhedral nucleocapsid along with a helical tail and attachment fibers

Multiplication Cycle in Bacteriophages
Multiplication goes through similar stages as animal viruses!
Only the nucleic acid enters (through direct penetration) the cytoplasm
Release due to cell lysis = lytic cycle
Background - Bacteriophages: bacterial viruses (phages)
Most widely studied are those that infect Escherichia coli

Virus Host Range
Host cell infection → Due to affinity of viral surface proteins for complementary proteins (receptor) on host cell surface means:
Host cell must possess a receptor that interacts with viral surface → no host receptor = no binding/ no infectivity
SO host range is determined by the presence of the receptor/complementary molecule
Examples of host range: Rabies = mammals, T4 bacteriophage = one strain of E. coli (narrow)
Small number of people cannot catch HIV
5 Steps in Phage Replication (basic viral lifecycle)
True for ALL viruses
Absorption/Attachment: binding of virus to specific molecule/receptor on host cell
Penetration (entry): genome/nucleic acid enters host cell
Biosynthesis: viral components produced
All viruses use host ribosomes! (Protein synthesis and translation (RNA → proteins)
Maturation (spontaneous): Assembly and completion of viral formation
Release (exit): viruses leave cell via lysis to infect other cells
Burst time: time from attachment to lysis
Burst size: # of viral particles released
T4 Bacteriophage infects E. Coli = releases ~ 200 virions
Bacteriophage T4 (dsDNA) infecting Escherichia coli (gram neg. rod)
T4 produces lysozyme = weakens E. coli’s cell wall to allow viral tail penetration
LPS is a receptor for T4 on E.coli (gram negative)

Lytic vs. Lysogenic → Lifecycle Stages
Lytic Phase: makes progeny and lysis open the host cell → Happens under BAD environmental conditions
Lysogenic Phase: DNA of the virus enters host cell genome. Every time the host cell divides and copies its genome, the viral genome is copied too
The Lytic Replication Cycle in Bacteriophages
Maturation = spontaneous reaction but always in the same order!

Lysogeny: The Silent Virus Infection (LYSOGENIC CYCLE)
Some DNA phages, called lysogeny or temperate phages, undergo adsorption and penetration but don’t replicate (only first 2 of lytic cycle)
The viral DNA inserts into bacterial genome and becomes an inactive prophage
The prophage is retained and copied during normal cell division resulting in the transfer of temperate phage genome to ALL HOST CELL PROGENY (Lysogenic cycle)
Induction: activation of lysogenic prophage followed by viral replication and cell lysis
Causes = UV light/Chemicals/environmental cues
*Note: Lysogeny is longer than lytic = virus will stay in this cycle longer

The lysogenic cycle of bacteriophage in λ in E. coli
Absorption/attachment (both): Phage attaches to the host cell and injects DNA
Penetration (entry): Phage DNA circularizes and enters lytic cycle or lysogenic cycle (happens for both)
Step 3 is where we split off
3A: Biosynthesis/maturation: New phage DNA and proteins are synthesized and assembled into virions
3B: Integration: Phage DNA integrates within the bacterial chromosome by recombination, becoming a prophage
4A: Release: cell lyses, releasing phage virions
4B: Lysogenic bacterium reproduces normally
GOOD CONDITIONS: keeps dividing!
BAD CONDITIONS: Induction occurs (activation of lysogenic prophage followed by viral replication and cell lysis)
5B: Occasionally, the prophage may excise from the bacterial chromosome by another recombination event, initiating a lytic cycle
Temperatphage = do BOTH LIFECYCLES

Lysogeny and its impact
Results in the spread of the virus without killing the host cell
LESS DEADLY form of parasitism
IMPACT:
Phages can serve as transporters of bacterial genes from one bacterium to another = transduction
(2nd Mechanism) Allows bacteria to acquire new genes (transduction) = new proteins → New properties/new activities
HGT = Conjugation, Transduction, Transformation
Transduction by a bacteriophage
A phage infects the donor bacterial cell
Phage DNA and proteins are made, and the bacterial chromosome is broken into pieces
Occasionally during phage assembly, pieces of bacterial DNA are packaged in a phage capsid. Then the donor cell lyses and releases phage particles containing bacterial DNA
A phage carrying bacterial DNA infects a new host cell, the recipient cell
Recombination can occur, producing a recombinant cell with a genotype different from both the donor and recipient cells
Movement of genes from one bacteria to another by a virus → The amount of material is limited by the size of the capsid

Examples of viruses that MMR vaccines protect against
Measles: deadly, neurological effects, weakened immune system
Mumps: Keeping men from having children
Rubella (German Measles): Kills children in the womb, miscarriage, birth defects
Different types of Vaccines
Getting the virus:
Getting infected
Virus can replicate
All the protein all the genome (RNA/DNA)
Killed Vaccine
Grow the virus in tissue culture or eggs
Purify it → Kill it
All the protein all the genome
Attenuated Vaccine
Grow virus
Purify it → DON’T kill it
Damage it or take some genes (People with suppressed immune system don’t take it)
Almost all proteins almost all genome
mRNA Vaccine
Scientists gets sequence of viral genome
Make the mRNA to the spike protein
Lipid around mRNA → Ribosome to make spike proteins → Control the Poly A tail length
Coronavirus
World Health Organization (WHO) names coronavirus “severe acute respiratory syndrome coronavirus 2” (SARS-CoV-2)
Virus can be transmitted from animal to human (direct contact) and human to human (droplet)
Human-to-human transmission of virus is primarily through droplets that may travel up to 6-10ft from person to person!
Coughing, sneezing, or talking
Virus can become aerosolized (airborne) and remain viable for up to 3 hours in the air
Enveloped = easier to get rid of on surfaces!
Coronavirus Transmission
Indirect transmission via a fomite (anything that you touch) can occur since virus remain viable on surfaces ~3 days
Viral particles have been found in fecal samples but there is no evidence for fecal-oral transmission
Outdoors was safer = enveloped, RNA virus
Positive ssRNA Viruses vs. Negative ssRNA Viruses
NOTE: DNA viruses use ALL of the host cell stuff!
And all viruses use host ribosome for translation
Positive ssRNA: Can go straight to the ribosome
Genome looks like mRNA
Negative ssRNA: Must make complementary copy to make mRNA
Complementary to mRNA
BOTH negative and positive ssRNA use an RNA polymerase, which makes more mistakes than DNA polymerase = Viruses have a high mutation rate!
Genetic Drift: recombination of viruses from different species
5’ methyl Gaumine Cap: lets ribosome recognize it as mRNA
Poly A Tail: longer it is, more stable the mRNA is
Virus Characteristics (Spike (S))
There are four main structural proteins, BUT the most important one is spike (S) glycoproteins
S proteins protrude from the viral surface resembling a crown, or corona!
The genome also codes for 16 nonstructural proteins that are involved in viral replication, maturation, and release
NOTE: this slide has to do with SARS-CoV-2
Belongs to genus β-coronavirus, family Coronaviridae
It is an enveloped virus with an unsegmented single stranded postive-sense mRNA (+ssmRNA)

Entry into the host
Portals of entry include
Nasal and oral passages
Conjunctiva of the eyes
S-proteins on the viral envelope bind to angiotensin-converting enzyme (ACE2) on host cells. Which triggers either viral endocytosis, or membrane fusion and mRNA entry.
ACE2: proteins present in many tissues (including lungs, kidneys, heart, arteries, and the gastrointestinal tract)
Functions: lower blood pressure, control fluid balance, and regulating the inflammatory response
Disease Manifestations (SARS-CoV-2)
STAGE 1: Asymptomatic State: Incubation time (the time from exposure to first symptoms) median to 5 days, range 2 to 14 days
Virus can be detected and is shed by the host in droplets
Virus propagates, mild immune response initiated
Up to 80% of COVID-19 cases are asymptomatic, but about 60% of COVID cases are transmitted from asymptomatic individuals
~18% of Covid infections are symptomatic and progress to stage 2
STAGE 2: Upper Airway Response: Robust immune system - symptoms appear, which include cough, fever, shortness of breath, chills, muscle pain, loss of taste and/or smell, sore throat, nausea, diarrhea
STAGE 3: Hypoxia (decrease of O2 to the body): progression to acute respiratory distress syndrome (ARDS)
Critical care/hospitalization
Pneumonia: difficulty breathing, persistent chest pain/pressure, confusion, inability to stay awake, bluish lips or skin
Cytokine storm: leads to dramatic decrease in blood pressure, leaky blood vessels, formation of blood clots, organ failure
Disease Manifestation

How mRNA COVID-19 Vaccines work
Coronaviruses, including the one that causes COVID-19, are named for crown-like spike proteins on their surface, which are key targets for vaccines.
mRNA is genetic material that tells your body HOW to make proteins
The vaccine is made of mRNA wrapped in a coating that makes delivery easy and keeps the body from damaging it
Does not contain ANY virus
Does not change your DNA
How does it work? The mRNA vaccine teaches cells to make spike proteins. Later, if exposed to the real virus, the body recognizes it and fights it off

Virophage
Small virus that INFECTS VIRUSES
Mamavirus when infected: Deformed and sickened/less infective
Mamavirus (2008) - infected by a virophage = sputnik
Found in an amoeba in a water cooling tower

Prions
Discovered by Stanley Prusiner
Proteinaceous infections particle = slow/persistent/deadly neurological diseases
Inherited and transmissible by ingestion, transplant, and surgical instruments
Transmissible spongiform encephalopathies: sheep scrapie’s, Creutzfeldt-Jakob disease, Kuru, fatal familial insomnia, mad cow disease
BSE - bovine spongiform encephalopathy

Prions: PrPc and PrPSc
PrPc :normal cellular prion protein, in brain and CNS
Fxn: Involved in regulation of cell death and cell differentiation
PrPSc: scrapie protein (folded wrong); accumulates in brain cells, forming plaques/fibrils - serves as template = cause refolding of the normal PrPC proteins
Misfolds and makes everything else misfold
What is the difference between the normal protein vs. the prion?
Conformational change = folded differently no longer functional
VERY resistant to enzymes! = will stick around (major problem)
OUTCOME: neuronal damage in brain/CNS = DEATH OF THESE TISSUES

Human SE - KURU
Recognized in cannabalistic tribes in New Guinea
Progressive, Fatal neurological disease
Affects the CNS = mental derangement and loss of motor function
If tribe member died the women prepared body for burial: women would eat the brain, and children ate the feet

Human SE - Creutzfeldt-Jakob Disease (CJD)
Slow progressive dieases’s
Extremely rare disease (runs in families)
Usually person > 50 years old (unknowingly passes it on!)
Other ways CJD is acquired (vCJD)
Corneal transplant, growth hormones, surgical instruments (electrodes in brain), and ingestion of prion contaminated beef (all contamination)
Bovine (cattle) Spongiform (hole in brain = sponge) Encephalopathy (issues with brain) (BSE)
Also known as Mad Cow Disease!
First reported in Britain (1986) and linked to supplementing cattle food with bone meal and tissues of sheep!
In 1981 (slow acting process) = change in manufacturing process of cattle feed.
Eliminated treatment of feed with organic solvents = eliminated the important step that inactivated/destroyed prions

Prions resistant to and sensitive to
FIRSTLY prions are transferred during corneal implants, by growth hormones from cadaver pituitaries, surgical instruments, or ingestion of contaminated beef
They are resistant to: formaldehyde, ethanol, proteases (enzymes), ionizing radiation, cooking to 662ºF!
They are sensitive to: bleach, phenol, strong detergents, autoclaving (heat + pressure), organic solvents
Dairy is fine because there is no nervous tissue present and gelatin is made from cattle products BUT is fully processed

Plant Viruses and Viroids
Enters through wounds or via insects! (clean saws b/n cutting plants)
Viroids: infectious, circular ssRNA (not a virus)
Ex: potato spindle tuber disease or Avocado sunbloch viroid
Very small piece of naked RNA
ONLY associated with plant disease

Chronic Wasting Disease in Deer and Elk
CWD is a fatal, neurodegenerative disease that affects deer, elk, and moose in North America. It is caused by a misfolded protein called a prion.
Transmission:
CWD is spread through direct contact with infected animals or their bodily fluids, such as saliva, urine, or feces. It can also be transmitted through contaminated soil or vegetation. (Deer hunters eating meat from elk/deer

Comparisons of Viruses, Viroids, and Prions to Bacterial Cells


Filamentous Helical (Virus Shape)
Rigid Helical: Tubalovirus
Flexible Helical: Ebola
Only a couple pics because not a lot of people want to work with it


Icosahedral (Virus Shape)
Icosahedral: Adenovirus
Spike proteins (pleplomere)

Enveloped
Enveloped = Herpes and smallpox
The envelope is taken from the host cell!

Head and Tail (complex)
Complex = Bacteriophage
Viruses that only infect bacteria
T4 phage
lamba phage

Enveloped Viruses - Bacteria and Animal Cells
Bacteria, plants, fungi and protists cannot have enveloped viruses!
This is due to their cell walls!!
Animal cells can have enveloped viruses due to only having cell membranes and no cell walls